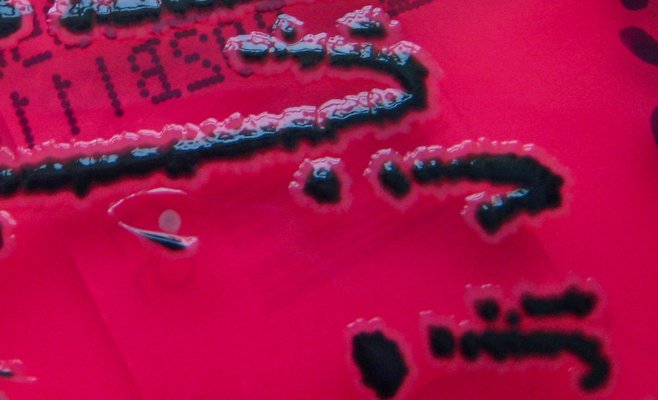
Редкая бактерия сальмонеллы обнаружена в Чехии

В Остраве запретили провозить электросамокаты и электровелосипеды в общественном транспорте: причина — опасность пожара
Популярное
С 1 октября жители Остравы больше не смогут брать с собой электросамокаты и электровелосипеды в трамваи, троллейбусы и автобусы. Новое правило ввёл Департамент общественного транспорта Остравы (DPO), объяснив это соображениями безопасности. Похожие ограничения уже действуют в ряде чешских городов — в Брно, Мосте, Усти-над-Лабем и Таборе.
Безопасность пассажиров — приоритет
«По примеру крупных европейских городов — таких как Лондон и Берлин — мы повышаем безопасность пассажиров. Поэтому с октября перевозка электросамокатов и электровелосипедов в транспорте Ostrava MHD запрещена», — заявила пресс-секретарь транспортного предприятия Тереза Шноблова.
По её словам, меры направлены на предотвращение возгораний в замкнутом пространстве салонов. При этом запрет не распространяется на электрические инвалидные коляски и скутеры для пожилых людей.
«Риск возгорания у электросамокатов и электровелосипедов гораздо выше, чем у колясок, которых, к тому же, в эксплуатации значительно меньше. Для людей с ограниченной подвижностью это не выбор, а зачастую единственный способ передвижения», — добавила Шноблова.
Почему боятся батарей
Решение властей напрямую связано с рядом инцидентов, произошедших в последние годы. Один из самых громких случаев — взрыв электросамоката в жилом доме в Остраве, после которого женщина спаслась, спускаясь по громоотводу, а её собака погибла в огне.
«Наши транспортные средства оснащены современными батарейными системами, которые постоянно контролируются датчиками и защищены автоматическими средствами тушения. Поэтому бояться батарей в трамваях и автобусах не стоит», — уточнила пресс-секретарь DPO.
Нарушителям грозит штраф
Пассажиров, решивших проигнорировать запрет, ждут последствия. «Если человек попытается провезти электросамокат или электровелосипед, он нарушит договорные условия перевозки. Такой пассажир может быть высажен из транспорта и в некоторых случаях оштрафован», — предупредила Шноблова.
Мнение пожарных
Запрет полностью поддержали морско-силезские пожарные, несмотря на то, что пока в регионе не зафиксировано случаев возгорания таких устройств в общественном транспорте.
«Наш опыт показывает, что примерно половина пожаров электросамокатов и электровелосипедов происходит во время зарядки. Остальные — при хранении или эксплуатации», — пояснила представитель пожарного корпуса Камила Лангерова.
По её словам, батареи способны воспламениться даже при выключенном состоянии, если устройство находится в замкнутом пространстве. «Из-за высокой интенсивности и динамики возгораний литиевых батарей мы не рекомендуем их перевозку в закрытых помещениях, откуда пассажиры не могут немедленно эвакуироваться — например, в лифтах или общественном транспорте», — добавила она.
Тревожная статистика
С начала года на севере Моравии и в Силезии произошло 16 пожаров транспортных средств с аккумуляторным питанием, из них 11 — внутри помещений. В результате пострадало 11 человек, ещё 25 удалось спасти. Ущерб от этих инцидентов превысил 5,5 миллиона крон.